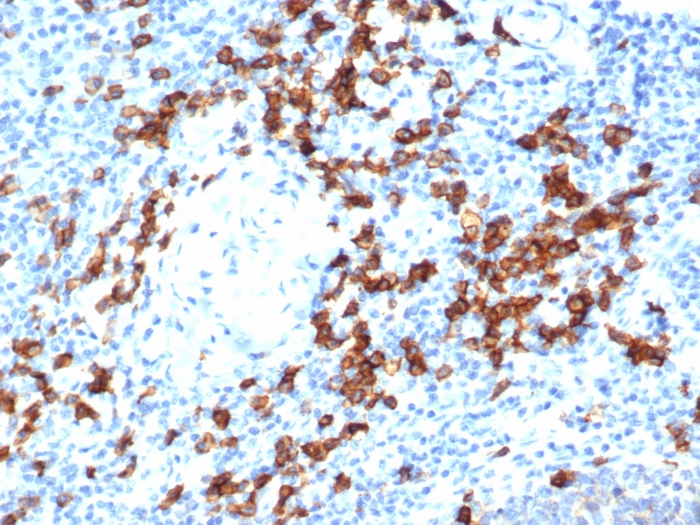

IHC analysis of formalin-fixed, paraffin-embedded human tonsil. Strong cytoplasmic and membranous staining using rCD38/6447 at 2ug/ml in PBS for 30min RT. HIER: Tris/EDTA, pH9.0, 45min. 2°C: HRP-polymer, 30min. DAB, 5min.

IHC analysis of formalin-fixed, paraffin-embedded human brain. Negative tissue control using rCD38/6447 at 2ug/ml in PBS for 30min RT. HIER: Tris/EDTA, pH9.0, 45min. 2°C: HRP-polymer, 30min. DAB, 5min.

IHC analysis of formalin-fixed, paraffin-embedded human prostate adenocarcinoma. Strong cytoplasmic and membranous staining using rCD38/6447 at 2ug/ml in PBS for 30min RT. HIER: Tris/EDTA, pH9.0, 45min. 2°C: HRP-polymer, 30min. DAB, 5min.
CD38 is a type II transmembrane glycoprotein that is present on early B- and T-cell lineages and activated B- and T-cells but is absent from most mature resting peripheral lymphocytes. CD38 is found on thymocytes, pre-B cells, germinal center B-cells, mitogen-activated T-cells, monocytes and Ig-secreting plasma cells. CD38 is expressed on CD34+ cells. The CD34+CD38- population of hematopoietic stems cells define the most pluripotent cells (e.g.blast colony forming cells).
There are no reviews yet.